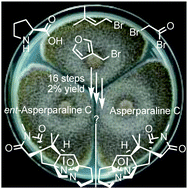
Graphical abstract: First total synthesis of ent-asperparaline C and assignment of the absolute configuration of asperparaline C

First total synthesis of ent-asperparaline C and assignment of the absolute configuration of asperparaline C†
Abstract
The first asymmetric total synthesis of a member of the asperparaline family was accomplished and the unknown absolute configuration of asperparaline C has been determined to be all-(S). The key steps of the synthesis are an oxidative radical cyclization, a selective reduction of one of the tertiary amides, a singlet oxygen Diels–Alder reaction and a reductive spirocyclization.

- This article is part of the themed collection: Natural product synthesis

Please wait while we load your content...
Please wait while we load your content...